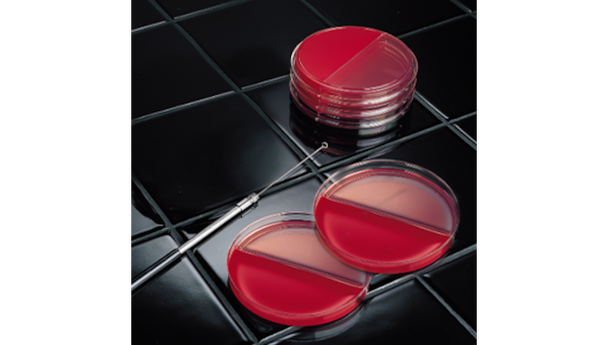
BD BBL Prepared Culture Media Plate – Dual Media Formulation, 98-Day Shelf Life, Prepared Culture Media

Description
BD BBL Prepared Culture Media Plate is designed for laboratories that need reliable, ready-to-use media for efficient microbial growth. This product supports technicians and researchers seeking consistent results and streamlined workflows. With its dual media formulation, it is ideal for clinical labs and research settings where accuracy and efficiency are essential.
- Dual Media Formulation – Offers two BD BBL media types in one plate, supporting a wide range of microbial cultures for dependable results.
- Ample Surface Area – Provides sufficient space for easy inoculation and luxuriant microbial growth, helping users achieve clear outcomes.
- Labor-Saving Design – Reduces manual preparation time, allowing staff to focus on analysis and interpretation for a smoother workflow.
- Cost-Efficient Solution – Lowers supply costs and reduces waste, supporting budget-conscious labs.
Optimized Microbiology Plate for Reliable Results
This prepared culture media plate combines two high-quality BD BBL media formulations in a single dish, making it a practical choice for laboratories focused on diagnostic accuracy and efficiency. The large surface area simplifies inoculation and supports clear, luxuriant growth, which is critical for consistent microbial identification. Designed for use in clinical and research labs, this plate helps reduce manual preparation, saving time and resources. Its dual media setup supports a broad range of testing needs, making it a versatile tool for microbiology professionals. The 98-day shelf life ensures product reliability and minimizes waste, giving users confidence in their daily routines.
Features and Benefits
Enhanced Laboratory Efficiency
- Ready-to-Use Format – Eliminates the need for manual media preparation, streamlining laboratory processes.
- Consistent Quality – Manufactured to deliver uniform results, supporting reproducible outcomes in every batch.
Versatile Microbial Support
- Dual Media Types – Accommodates a variety of microorganisms, expanding testing capabilities for labs.
- Clear Growth Visualization – Promotes luxuriant colony development for easier interpretation and analysis.
Cost and Waste Reduction
- Labor Savings – Reduces hands-on time, allowing staff to focus on critical tasks.
- Lower Supply Costs – Minimizes resource use and waste, supporting sustainable lab operations.
Product Specifications
Identification and Shelf Life
- SKU: 221291
- GTIN (Each): 00382902212911
- Shelf Life: 98 days
Packaging and Category
- Category: Prepared culture media
- GTIN (Bag): 10382902212918
- GTIN (Shelfpack): 30382902212912
- GTIN (US Standard Pallet): 60382902212913
Explore More: See all Prepared Culture Media | Shop more BD BBL Products
Reliable Performance for Laboratory Professionals
This plate stands out for its dual media design and long shelf life, offering a dependable solution for labs that value efficiency and accuracy. The ready-to-use format means less time spent on preparation and more time focused on results. Its consistent quality and cost-saving features make it a smart choice for busy laboratory environments. You can trust this product to support your daily testing needs with confidence and ease.
- Dual Media Advantage – Supports a broader range of tests compared to single-media plates, giving labs more flexibility.
- Long Shelf Life – 98-day storage period reduces waste and ensures product availability when needed.
- Consistent Results – Uniform manufacturing standards help deliver reliable outcomes for every batch.
- Streamlined Workflow – Ready-to-use design saves time and simplifies daily lab routines.
Frequently Asked Questions (FAQs)
What is the main benefit of the BD BBL Prepared Culture Media Plate?
The main benefit is its dual media formulation, which allows for multiple microbial tests in one plate, saving time and resources.
How long is the shelf life of this culture media plate?
The shelf life is 98 days, helping labs plan inventory and reduce waste.
Is the plate ready to use upon arrival?
Yes, this product is supplied in a ready-to-use format, eliminating the need for manual preparation.
What types of laboratories can use this plate?
This plate is suitable for clinical and research laboratories that require reliable and efficient microbial growth media.
Does the plate support a wide range of microorganisms?
Yes, the dual media design accommodates various microorganisms, supporting diverse testing needs.
How does this product help reduce laboratory costs?
Its labor-saving and cost-efficient design lowers supply expenses and minimizes waste in the lab.
What is the SKU for ordering this product?
The SKU is 221291, which can be used for reference when placing orders.